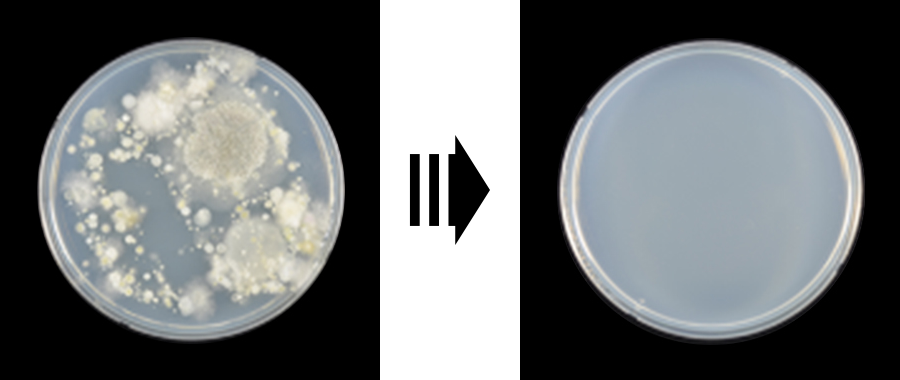

Hospital / Office
Filter contamination is a problem!
Replacing the filter every day is cumbersome...
100% sterilization of germs and viruses that cause filter contamination. Everyday!
-
No chemicals harmful to human body are used. No ozone was generated.
-
Sterilization of ceramic filters daily in the safest way of heat sterilization
Ceramic filter
sterilization test
(Laboratory of Fungi System Classification, Department of Life Sciences, Seoul National University)

Conventional air purifier (HEPA filter)
Khanfilter (ceramic filter)
Hospital
-
Prevents the spread of germs and viruses with clean filters, sterilized every morning
-
Purifies the air in the examination room, patient’s room, waiting room, and laboratory and removes unpleasant odors
-
Protects the health of patients, caregivers, and medical staff from germs and viruses
-
In particular, it has a great effect on removing odors and viruses in elderly care hospitals with many seniors.
Office
-
Safely controls office facilities where many people come and go from PM, germs, and viruses
-
Continuously maintains clean office air with a clean filter, sterilized every morning
-
Protects employees’ health and improves work efficiency by creating a pleasant working environment